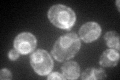
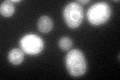

View description
Phosphatidylinositol phosphate (PtdInsP) phosphatase involved in hydrolysis of PtdIns[4]P; transmembrane protein localizes to ER and Golgi; involved in protein trafficking and processing, secretion, and cell wall maintenance
Localization:
Intensity:
Fold change:
Significance:
-
C’ GFP library in SD
ER78.9 -
N' NOP1pr-GFP in SD

ER216.939 -
N' TEF2pr-mCherry in SD

missing0 -
N' NATIVEpr-GFP in SD

missing0 -
N' TEF2pr-VC and Cyto-VN in SD

ER61.1634 -
C’ GFP library in SD+DTT
ER69.960.88No -
C’ GFP library in SD+H2O2

ER80.541.02No -
C’ GFP library in Starvation Media

ER64.210.81No -
C’ GFP library on the background of Pup2-DaMP

ER -
C’ GFP library on the background of CCT mutant

ER63.74990.807834No
